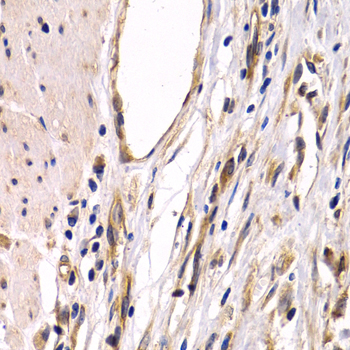
A5342: image 3

For quotations, please use our online quotation form, and you may also contact us by
sales@neoscientific.com
+1-888.733.6849
+1-617.299.7367 (Int’l)
+1-888.733.6849
+1-617.299.7367 (Int’l)
| Reactivity | Human Mouse Rat |
| Tested applications | WB IHC IF |
| Recommended Dilution | WB 1:500 - 1:2000 IHC 1:50 - 1:200 IF 1:50 - 1:200 |
| Calculated MW | 52kDa |
| Observed MW | Refer to Figures |
| Immunogen | Recombinant protein of human G3BP1 |
| Storage Buffer | Store at -20℃. Avoid freeze / thaw cycles. Buffer: PBS with 0.02% sodium azide, 50% glycerol, pH7.3. |
| Concentration | j |
| Synonym | G3BP; HDH-VIII; |

Western blot analysis of extracts of various cell lines, using G3BP1 antibody.

Immunohistochemistry of paraffin-embedded human colon damage using G3BP1 antibody at dilution of 1:200 (400x lens).
Immunohistochemistry of paraffin-embedded human stomach cancer using G3BP1 antibody at dilution of 1:200 (400x lens).

Immunofluorescence analysis of U20S cell using G3BP1 antibody. Blue: DAPI for nuclear staining.
This gene encodes one of the DNA-unwinding enzymes which prefers partially unwound 3'-tailed substrates and can also unwind partial RNA/DNA and RNA/RNA duplexes in an ATP-dependent fashion. This enzyme is a member of the heterogeneous nuclear RNA-binding proteins and is also an element of the Ras signal transduction pathway. It binds specifically to the Ras-GTPase-activating protein by associating with its SH3 domain. Several alternatively spliced transcript variants of this gene have been described, but the full-length nature of some of these variants has not been determined.
N/A